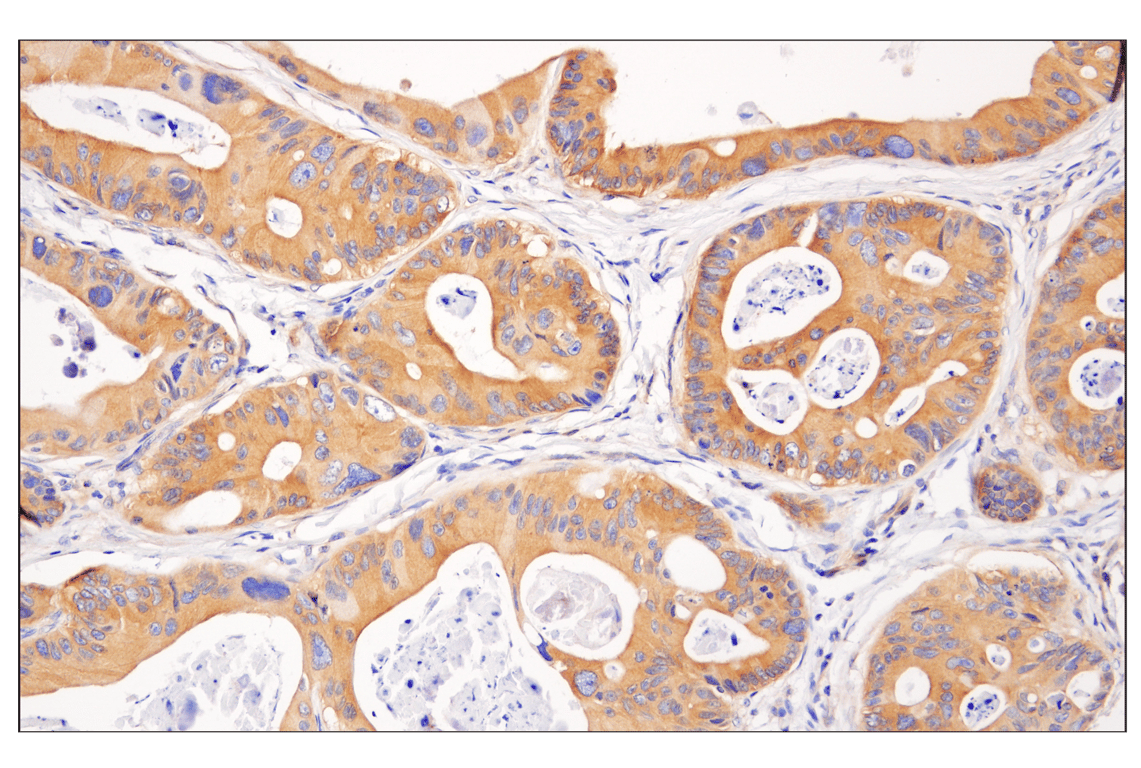
undefined Image 24: PPAR gamma Regulated Fatty Acid Metabolism Antibody Sampler Kit

Revision 1
#8660
Store at -20C
PPAR gamma Regulated Fatty Acid Metabolism Antibody Sampler Kit
1 Kit
(7 x 20 microliters)
877-616-CELL (2355)
877-678-TECH (8324)
3 Trask Lane | Danvers | Massachusetts | 01923 | USA
For Research Use Only. Not for Use in Diagnostic Procedures.
| Product Includes | Product # | Quantity | Mol. Wt | Isotype/Source |
|---|---|---|---|---|
| Phospho-AMPK alpha (Thr172) (40H9) Rabbit Monoclonal Antibody | 2535 | 20 µl | 62 kDa | Rabbit IgG |
| AMPK alpha (D5A2) Rabbit Monoclonal Antibody | 5831 | 20 µl | 62 kDa | Rabbit IgG |
| CBP (D6C5) Rabbit Monoclonal Antibody | 7389 | 20 µl | 300 kDa | Rabbit IgG |
| GCN5L2 (C26A10) Rabbit Monoclonal Antibody | 3305 | 20 µl | 94 kDa | Rabbit IgG |
| PPAR gamma (C26H12) Rabbit Monoclonal Antibody | 2435 | 20 µl | 53, 57 kDa | Rabbit IgG |
| SirT1 (C14H4) Rabbit Monoclonal Antibody | 2496 | 20 µl | 120 kDa | Rabbit |
| RXR alpha (D6H10) Rabbit Monoclonal Antibody | 3085 | 20 µl | 53 kDa | Rabbit IgG |
| Anti-rabbit IgG, HRP-linked Antibody | 7074 | 100 µl | Goat |
Please visit cellsignal.com for individual component applications, species cross-reactivity, dilutions, protocols, and additional product information.
Description
Storage
Background
CBP (CREB-binding protein) is a transcriptional co-activator that associates with PPARγ (6,7). CBP also contains histone acetyltransferase (HAT) activity, allowing it to acetylate histones and other proteins (7).
General Control of Amino Acid Synthesis Yeast Homolog Like 2 (GCN5L2) is a transcription adaptor protein and a histone acetyltransferase (HAT) that functions as the catalytic subunit of the STAGA and TFTC transcription coactivator complexes (8). GCN5L2 is 73% homologous to the p300/CBP-associated factor PCAF, another HAT protein found in similar complexes (9). GCN5L2 acetylates non-histone proteins such as the transcription co-activator PGC1-α (10).
Peroxisome proliferator-activated receptor γ (PPARγ) is a member of the ligand-activated nuclear receptor superfamily and functions as a transcriptional activator (11). PPARγ is preferentially expressed in adipocytes as well as in vascular smooth muscle cells and macrophage (12).
The Silent Information Regulator (SIR2) family of genes is a highly conserved group of genes that encode nicotinamide adenine dinucleotide (NAD)-dependent protein deacetylases, also known as class III histone deacetylases (13). SirT1, the mammalian ortholog of Sir2, is a nuclear protein implicated in the regulation of many cellular processes, including apoptosis, cellular senescence, endocrine signaling, glucose homeostasis, aging, and longevity. Targets of SirT1 include PPARγ (14), and the PPARγ coactivator-1α (PGC-1α) protein (15). Deacetylation of PPARγ and PGC-1α regulates the gluconeogenic/glycolytic pathways in the liver and fat mobilization in white adipocytes in response to fasting (14,15).
The human retinoid X receptors (RXRs) are type-II nuclear hormone receptors encoded by three distinct genes (RXRα, RXRβ, and RXRγ) and bind selectively and with high affinity to the vitamin A derivative, 9-cis-retinoic acid. Nuclear RXRs form heterodimers with PPAR to help regulate transcription during lipid metabolism (16).
Background References
- Carling, D. (2004) Trends Biochem Sci 29, 18-24.
- Hawley, S.A. et al. (1996) J Biol Chem 271, 27879-87.
- Lizcano, J.M. et al. (2004) EMBO J 23, 833-43.
- Shaw, R.J. et al. (2004) Proc Natl Acad Sci U S A 101, 3329-35.
- Hardie, D.G. (2004) J Cell Sci 117, 5479-87.
- Goodman, R.H. and Smolik, S. (2000) Genes Dev 14, 1553-77.
- Chan, H.M. and La Thangue, N.B. (2001) J Cell Sci 114, 2363-73.
- Candau, R. et al. (1996) Mol Cell Biol 16, 593-602.
- Yang, X.J. et al. (1996) Nature 382, 319-24.
- Lerin, C. et al. (2006) Cell Metab 3, 429-38.
- Tontonoz, P. et al. (1995) Curr Opin Genet Dev 5, 571-6.
- Rosen, E.D. et al. (1999) Mol Cell 4, 611-7.
- Guarente, L. (1999) Nat Genet 23, 281-5.
- Picard, F. et al. (2004) Nature 429, 771-6.
- Rodgers, J.T. et al. (2005) Nature 434, 113-8.
- Gronemeyer, H. et al. (2004) Nat Rev Drug Discov 3, 950-64.
Trademarks and Patents
Cell Signaling Technology is a trademark of Cell Signaling Technology, Inc.
U.S. Patent No. 7,429,487, foreign equivalents, and child patents deriving therefrom.
All other trademarks are the property of their respective owners. Visit cellsignal.com/trademarks for more information.
Limited Uses
Except as otherwise expressly agreed in a writing signed by a legally authorized representative of CST, the following terms apply to Products provided by CST, its affiliates or its distributors. Any Customer's terms and conditions that are in addition to, or different from, those contained herein, unless separately accepted in writing by a legally authorized representative of CST, are rejected and are of no force or effect.
Products are labeled with For Research Use Only or a similar labeling statement and have not been approved, cleared, or licensed by the FDA or other regulatory foreign or domestic entity, for any purpose. Customer shall not use any Product for any diagnostic or therapeutic purpose, or otherwise in any manner that conflicts with its labeling statement. Products sold or licensed by CST are provided for Customer as the end-user and solely for research and development uses. Any use of Product for diagnostic, prophylactic or therapeutic purposes, or any purchase of Product for resale (alone or as a component) or other commercial purpose, requires a separate license from CST. Customer shall (a) not sell, license, loan, donate or otherwise transfer or make available any Product to any third party, whether alone or in combination with other materials, or use the Products to manufacture any commercial products, (b) not copy, modify, reverse engineer, decompile, disassemble or otherwise attempt to discover the underlying structure or technology of the Products, or use the Products for the purpose of developing any products or services that would compete with CST products or services, (c) not alter or remove from the Products any trademarks, trade names, logos, patent or copyright notices or markings, (d) use the Products solely in accordance with CST Product Terms of Sale and any applicable documentation, and (e) comply with any license, terms of service or similar agreement with respect to any third party products or services used by Customer in connection with the Products.
Revision 1



Revision 1



Revision 1



Revision 1



Revision 1



Revision 1



Revision 1



Revision 1

Revision 1



Revision 1



Revision 1



Revision 1



Revision 1



Revision 1



Revision 1
